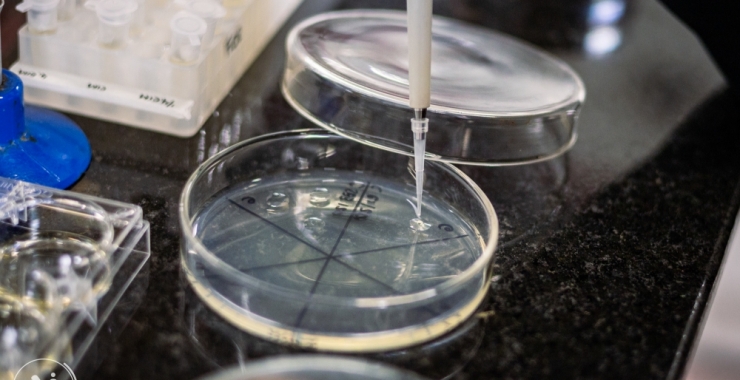
Brasil financia proyectos científicos regionales

Brasil financia proyectos científicos regionales
Se realizó el lanzamiento de la convocatoria pública del programa PROSUL «Pepe Mujica», una iniciativa de cooperación científica y tecnológica entre Brasil y América Latina que cuenta con cuota reservada para universidades de la AUGM, representando una oportunidad directa para nuestra Institución.